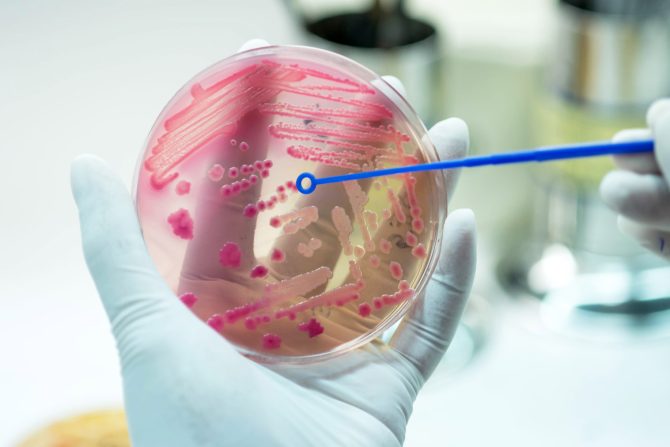
bakterije

Ovo mesto u kuhinji je pravi rasadnik bakterija kao što su salmonela i ešerihija: Kako da sprečite razvoj infekcije
Ešerihija koli, salmonela i listerija najčešće su bakterije koje mogu da dovedu do tegoba ili bolesti
Bakterije su mikroorganizmi koji nastanjuju naše telo i spoljašnju sredinu. Nisu uvek štetne; dobre bakterije sprečavaju razvoj loših bakterija koje mogu da izazovu bolest. Crevne infekcije su neke od najčešćih bakterijskih infekcija, zovu se i bolest prljavih ruku, i to sa dobrim razlogom.
Bakterije mogu da se zaglave na priboru za pranje
Kuhinjska sudopera je sigurna luka za bakterije, ali i prostor nad kojim peremo ruke, suđe, voće i povrće, meso. Sudopera je i deo kuhinje sa sunđerima i četkama za ribanje na kojima uvek može da se nađe deo bakterija.
- Većina mikroorganizama se tokom pranja ispere, ali deo može da se uvek zaglavi na sunđeru za pranje, kuhinjskim krpama, drobilicama za smeće, ako ih sadrži sudopera - kaže Lester Schonberger, sa Virginia Tech Department of Food Science and Technology.
Sudopera je idealno stanište za bakterije
Sudopera sa toplim i vlažnim okruženjem idealna je sredina za razvoj bakterija. Schonberger smatra da se u sudoperi uvek može naći određeni broj mikroorganizama koji mogu da dovedu do bolesti.
Američka studija iz 2023. godine otkrila je da je 34 odsto kuhinjskih sudopera kontaminirano bakterijama posle pripreme obroka sa sirovim kobasicama, jajima i dinjom. Na više od jedne četvrtine dinje nađeni su ostaci bakterija posle pranja voća u sudoperi. Pretpostavlja se da su bakterije iz sudopere tokom pranja prešle na voće.
Otkriveni su tragovi fekalnih bakterija
Smatra se da kuhinjske sudopere mogu da budu dom za bakterije kao što su salmonela, ešerihija koli, listerija, posebno u odvodu, koji se retko čisti i dezinfikuje, navodi Kevin Roberts, Kansas State University.
- Skoro svaka bakterija koja može da se nađe u hrani može da završi i u sudoperi, što potvrđuju i istraživanja - kaže Kevin Roberts.
Manja studija iz 2022. godine, objavljena u časopisu Frontiers in Microbiology, u kojoj je ispitivano 10 domaćinstava, otkrila je patogene bakterije. Studija iz 2017. godine, rađena na uzorku od 100 domova, otkrila je fekalne koliformne bakterije (primarno nepatogene mikroorganizme) u 44 odsto uzoraka kuhinjskih sudopera, dok je 15 odsto bilo pozitivno na bakteriju Ešerihiju koli (lat. Escherichia coli).
Kuhinjske sudopere su savršeno mesto za razvoj ovakvih bakterija, smatra Mitzi Baum, predstavnica organizacije „Zaustavite bolesti koje se prenose hranom“. Sudopera je vlažna i topla sredina, sa komadićima hrane, i ako se redovno ne čisti, broj bakterija se umnožava.
Sunđeri za pranje takođe mogu da budu snažan izvor bakterija. Studija iz 2011. godine rađena u 22 porodice, otkrila je da je na 75 odsto sunđera i kuhinjskih krpa Ešerihiju koli, a na 45 odsto tragove salmonele (lat. Salmonella).
Mogu li bakterije iz sudopere da dovedu do razvoja bolesti?
Stručnjaci ističu da je unakrsna kontaminacija najveći problem.
- Ukoliko je pored namirnice kontaminirana i sudopera ili odvod, moguće je da dođe do razvoja infekcije - kaže Schonberger.
Na primer, ako "potopimo" lisnato povrće ili grožđe u sudoperu, moguće je da bakterije iz sudopere dospeju na hranu, ali i na okolne radne površine. Ešerihija koli, salmonela i listerija najčešće su bakterije koje mogu da dovedu do tegoba ili bolesti. Stručnjaci dodaju da u ovom slučaju ne postoji pravilo od pet sekundi, tokom kojih, kako se pogrešno pretpostavlja, neće doći do kontaminacije hrane.
Infekcija hranom
Infekcija hranom manifestuje se mučninom, povraćanjem, dijarejom, povišenom telesnom temperaturom, glavoboljom. Moguće je da dođe i do grčeva i slabosti u mišićima. Najosetljivije su osobe starije od 65 godina, deca mlađa od 5 godina, trudnice i osobe sa oslabljenim imunološkim sistemom.
- Ipak, i kada dođe do infekcije na ovaj način, većina osoba se brzo i potpuno oporavi - kaže Schonberger.
Kako pravilno očistiti (i dezinfikovati) sudoperu u kuhinji?
Jednostavno ispiranje neće uništiti mikroorganizme. Voda iz slavine neće ukloniti bakterije, pa čak i kada je vruća.
- Kako bismo sprečili unakrsnu kontaminaciju, sudoperu je potrebno redovno čistiti i dezinfikovati - smatra Roberts. On preporučuje pranje odgovarajućim deterdžentom i toplom vodom. Sapun se ispere, a sudopera potom osuši papirnim ubrusima. To što sudopera izgleda čisto, ne znači da je čista, opominju nas stručnjaci za higijenu.
eKlinika zadržava sva prava nad sadržajem. Za preuzimanje sadržaja pogledajte uputstva na stranici Uslovi korišćenja.


